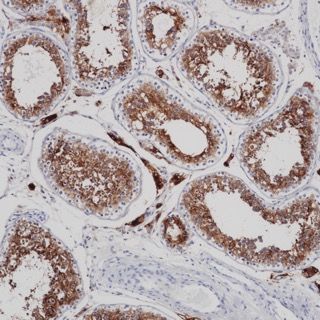
产品封面图

相关产品推荐更多 >
万千商家帮你免费找货
0 人在求购买到急需产品
- 详细信息
- 文献和实验
- 技术资料
- 保存条件:
Store at -20°C. Supplied in 50nM Tris-Glycine(pH 7.4), 0.15M NaCl, 40%Glycerol, 0.01% sodium azide and 0.05% BSA. Stable for 12 months from date of receipt.
- 适应物种:
Human
- 保质期:
12个月
- 库存:
现货
- 宿主:
Rabbit
- 应用范围:
IHC
- 靶点:
ACE2
- 规格:
100μL
风险提示:丁香通仅作为第三方平台,为商家信息发布提供平台空间。用户咨询产品时请注意保护个人信息及财产安全,合理判断,谨慎选购商品,商家和用户对交易行为负责。对于医疗器械类产品,请先查证核实企业经营资质和医疗器械产品注册证情况。
文献和实验Efficient Liposome-Mediated Gene Transfer to Rabbit Carotid Arteries In Vivo
Methods for gene delivery in vivo vary dramatically in their relative efficiencies. The most efficient to date involve the use of recombinant viruses, most notably adenoviruses, adeno-associated viruses (AAVs), or retroviruses (see Chapters
Recombinant Immunotoxins in the Treatment of Cancer
Recombinant immunotoxins are chimeric proteins composed of the Fv portion of a monoclonal antibody (MAb) fused to a portion of a toxin. The Fv replaces the cell-binding domain of the toxin and directs the toxin to cancer cells that express
Expression of Recombinant Antibodies in Mammalian Cell Lines
Since the advent of hybridoma technology, mammalian-cell culture has been employed for the expression and high-level production of monoclonal antibodies (MAbs). Recent adaptations in recombinant technology have developed the use of numerous
技术资料暂无技术资料 索取技术资料